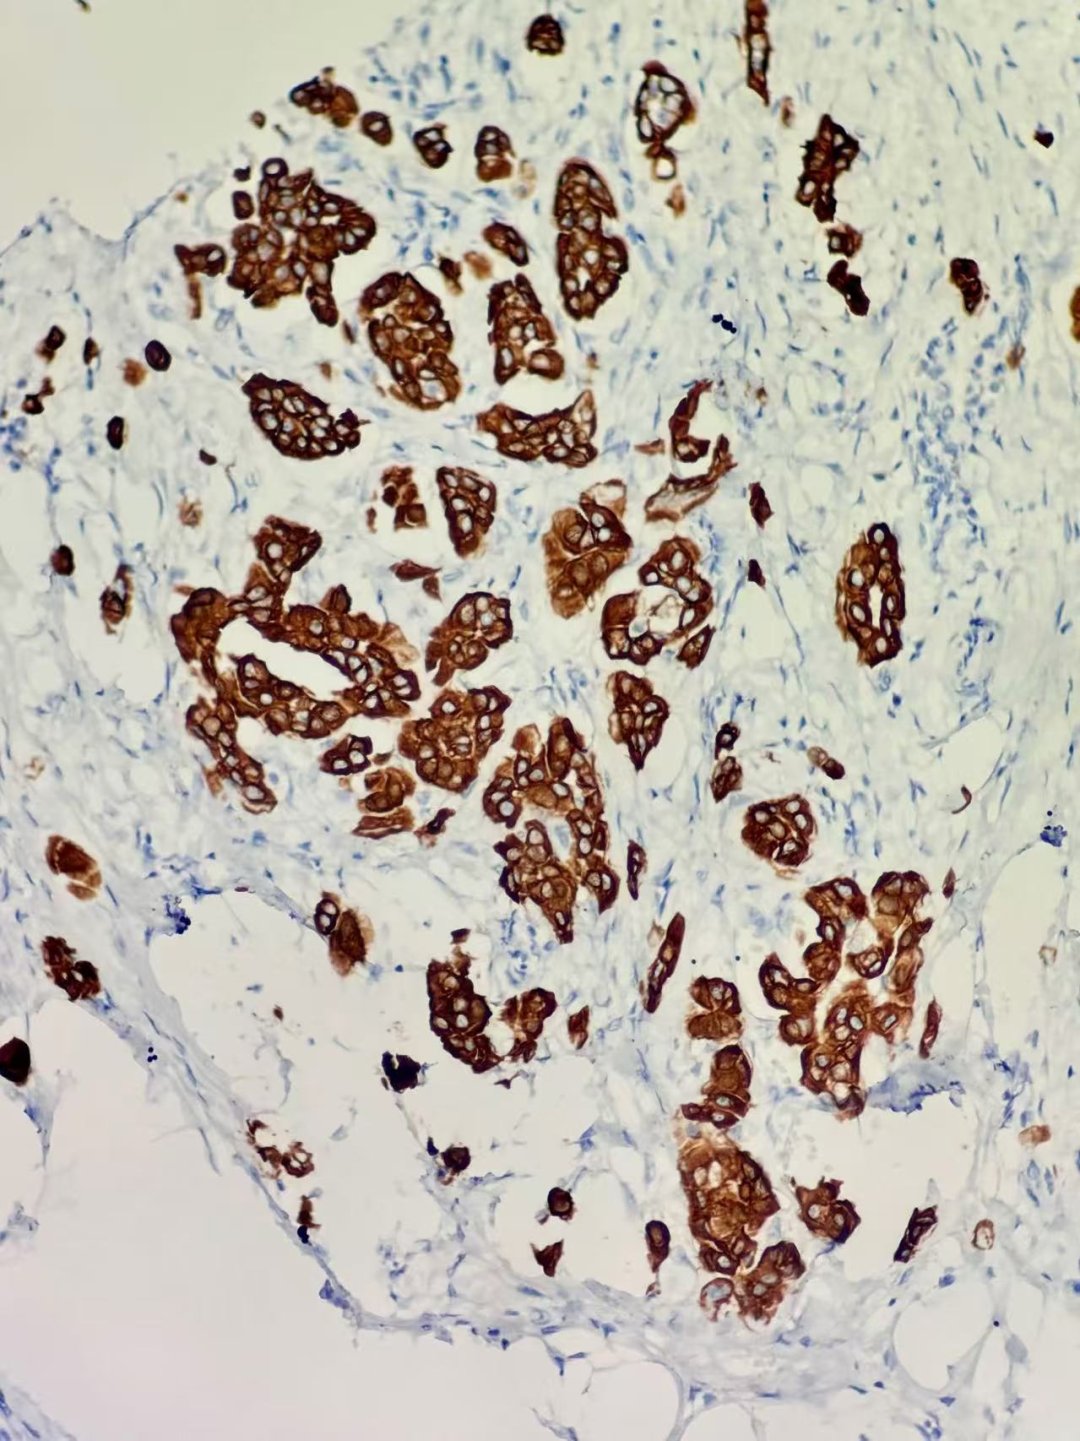
深入解析罕见乳腺癌:囊性高分泌性癌(CHC)的诊断、治疗与靶向药选择 6 图片

引言
乳腺癌是女性最常见的恶性肿瘤之一,其病理类型多样,其中囊性高分泌性癌(Cystic Hypersecretory Carcinoma, CHC)是一种极为罕见的亚型。准确诊断和理解其独特的病理生理学特征,对于制定有效的乳腺癌治疗方案至关重要。本文将通过一例伴有微浸润的CHC病例,深入探讨这种罕见乳腺癌的临床表现、诊断要点、病理特征、鉴别诊断以及治疗策略,并为患者提供关于靶向药、抗癌药及仿制药获取的实用信息。
囊性高分泌性癌(CHC)概述
囊性高分泌性病变是一组少见的乳腺疾病谱,涵盖了囊性高分泌性增生(CHH)、不典型囊性高分泌性增生(ACHH)和囊性高分泌性癌(CHC)。CHC作为其中的恶性病变,是乳腺导管癌的一种罕见变体。多数病例表现为原位癌,但少数可伴有浸润性癌成分,这使得其诊断和预后评估更具挑战性。
典型病例解析:诊断与病理特征
患者基本情况
一位68岁女性患者,因发现右侧乳腺肿块一月余入院。这提示了对乳腺肿块的早期关注和及时就医的重要性。
辅助检查发现
B超检查显示右侧乳腺存在约4.9×4.7×1.1cm的混合回声肿块,边界不清,内部回声不均匀,并伴有管状无回声区。外院乳腺钼靶检查曾误诊为慢性炎症性改变,这强调了对罕见病变进行多模态影像学评估和病理确诊的必要性。双侧腋窝未见明显增大淋巴结,初步排除了区域淋巴结转移的可能。
病理学观察
切除的乳腺组织呈灰白色,质地柔软,可见大小不等的囊腔,内含分泌物。镜下特征显示,正常乳腺导管及小叶结构消失,取而代之的是大小不等的囊腔,部分囊腔内可见乳头及微乳头结构,囊内充满嗜酸性分泌物。高倍镜下,囊内衬上皮细胞呈中—重度异型性,核深染,核质比增高,偶见核仁。值得注意的是,局部查见两处约0.5mm的微浸润癌病灶,这对于后续的治疗方案选择具有指导意义。

图1 正常乳腺导管及小叶结构消失,可见大小不等的囊腔,部分囊腔内见乳头及微乳头,囊内充满嗜酸性分泌物HE中倍放大

图2 囊内衬上皮细胞中—重度异型,单层或复层排列,核深染,核质比增高,部分可见核仁,核分裂象不易见HE高倍放大

图3 局部可见微浸润癌病灶HE高倍放大
免疫组化与分子特征
免疫组化结果对于乳腺癌的分子分型和治疗选择至关重要。本病例显示:
- ER(雌激素受体):微浸润癌个别细胞阳性,原位癌约40%阳性。
- PR(孕激素受体):微浸润癌及原位癌均阴性。
- HER-2(人表皮生长因子受体2):0(阴性)。
- P53:野生型(+)。
- Ki67:增殖指数约5%,提示肿瘤细胞增殖活性较低。
- CK5/6及P63:原位癌肌上皮存在,微浸润癌肌上皮缺失,这有助于区分原位癌和浸润癌。
文献报道,部分CHC病例可能显示雄激素受体(AR)过表达,且TP53基因突变可能与非典型增生及癌变相关。这些分子特征为靶向治疗提供了潜在方向。

图4 p63染色示原位囊性高分泌癌肌上皮存在 EnVision法中倍放大

图5 p63染色示微浸润癌肌上皮缺失 EnVision法 高倍放大
图6 CK5/6染色示微浸润癌阳性 EnVision法 高倍放大
最终病理诊断与治疗
综合各项检查,患者最终被诊断为右侧乳腺原位囊性高分泌性癌伴两灶微浸润癌。患者接受了右侧乳腺单切手术及右侧腋窝前哨淋巴结活检。术后病理证实原切口有少量原位癌残留,局部见一处微浸润癌,乳头下大导管查见原位癌,各切缘未见癌。前哨淋巴结未见癌转移(0/4),病理分期为T1miN0Mx。术后,患者口服来曲唑进行内分泌治疗。随访至2025年2月28日,患者未见复发,显示了早期诊断和规范治疗的重要性。
CHC的鉴别诊断要点
由于CHC的罕见性和形态学特点,其鉴别诊断至关重要,需与多种乳腺病变区分:
- 黏液癌(Mucinous Carcinoma):两者均有囊性结构和分泌物,但黏液癌分泌物为细胞外黏液,且缺乏CHC特有的嗜酸性均质甲状腺胶样分泌物及囊内乳头状生长模式。免疫组化上,黏液癌肌上皮缺失,而CHC原位癌肌上皮存在。
- 分泌性癌(Secretory Carcinoma):虽有囊肿样改变和分泌性成分,但分泌性癌具有特征性的ETV6-NTRK融合基因,且Pan-TRK、S100阳性,这些在CHC中不常见。
- 良性囊性病变:如纤维囊性变、黏液囊肿样病变,其囊壁被覆单层扁平或立方上皮,无异型性。良性病变腺上皮部分表达CK5/6,而CHC腺上皮有异型性且不表达CK5/6。
- 转移性甲状腺癌:两者均可呈囊性并含甲状腺胶样分泌物。鉴别关键在于甲状腺癌表达甲状腺特异性标志物TTF-1、TG,而CHC不表达。
CHC的临床行为与预后
尽管原位CHC通常预后良好,病程惰性,但其仍具有潜在的侵袭性和转移能力。部分伴有浸润癌的病例可能发生淋巴结或远处转移。由于病例有限,CHC的长期预后尚需更多数据进行长期随访和研究。
靶向药与抗癌药在乳腺癌治疗中的作用
随着医学的进步,靶向药和新型抗癌药在乳腺癌治疗中扮演着越来越重要的角色。例如,对于激素受体阳性的乳腺癌,来曲唑等内分泌治疗药物是标准选择。而对于HER-2阳性或存在特定基因突变(如TP53、ETV6-NTRK融合基因)的患者,则有相应的靶向治疗药物可供选择。这些药物能够精准作用于癌细胞的特定靶点,提高治疗效果,同时减少对正常细胞的损伤,从而改善患者的生活质量。
获取海外靶向药与抗癌药的途径
面对罕见乳腺癌或国内尚未上市的靶向药、抗癌药,许多患者会考虑海外购药。专业的海外靶向药代购服务可以帮助患者合法、安全地获取所需的海外仿制药或原研药,解决哪里购买、价格等问题。此外,通过AI问诊服务,患者可以获得初步的用药建议和疾病信息,结合药物信息与诊疗指南,更好地了解治疗方案,为抗癌之路提供全面支持。
结语
囊性高分泌性癌(CHC)作为一种罕见乳腺癌亚型,其准确诊断和个性化治疗至关重要。通过深入了解其病理特征和分子分型,结合先进的靶向药和抗癌药,患者有望获得更好的治疗效果和生活质量。我们鼓励患者积极寻求专业医疗建议,并探索所有可行的治疗途径,包括通过正规渠道获取海外靶向药和仿制药,为战胜癌症争取更多希望。
